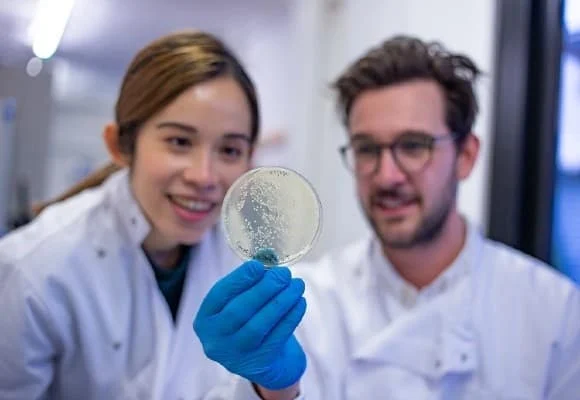
Better-Dairy

Seaspiracy made you think to switch to vegan seafood? Or the Netflix anti-fishing documentary and also Cowspiracy forced you to consider becoming a vegan completely? Well, you’re not alone!
Global searches for ‘vegan seafood’ have skyrocketed since the movie debut and seems to be changing people’s perception of seafood. At the same time, if we look at the UK meat alternative market, it was valued at $489.2 million in 2019 and is expected to hit $726.8 million in 2025, growing at an estimated CAGR of 6.8% between 2020 – 2025.
In terms of revenue, this accounts for nearly 30% of the total European meat alternative market. In 2018, the UK claimed the top spot, globally, for the number of vegan new product development launches. In figures, this meant 16% of all new food products launched were vegan, doubling from 8% in 2015.
Sustainable alternatives to conventional animal-based foods are attracting substantial investment. According to GFI’s fermentation state of the industry report, alternative protein companies raised $1.5 billion in the first seven months of 2020.
Innovators such as Impossible Foods and Perfect Day have pioneered tasty, sustainable alternatives to animal protein using fermentation technology. Following on the same, we take a look at which are the main players in the UK tech market tapping the industry.

AgriProtein
Founder/s: David Drew, Jason Drew
Founded year: 2008
Funding: £94.4M
Demand for fishmeal is expected to outspace supply by 5 million tonnes by 2024. Over 90 million tonnes of fishmeal is captured every year. Guildford-based AgriProtein is working to produce 100% natural, sustainable insect protein alternative to fishmeal for use in aquaculture feed.
In 2018, the insect farming business raised $105 million (nearly £77 million) in equity and debt. This marked the largest capital raised back then in the insect farming industry.

3FBio
Founder/s: Craig Johnston, Jim Laird
Founded year: 2015
Funding: £23.8M
3FBio is a food-tech company based in Glasgow that makes protein from sustainable sources. It uses grains to produce different by-products such as protein and ethanol, which is used as fuel to run the process using the patented integrated fermentation process.
Back in 2019, 3FBio bagged €17 million (nearly £15 million) backing from European Innovation Council for the first integrated bio-based protein biorefinery.

Deep Branch Biotechnology
Founder/s: Peter Rowe, Robert Mansfield
Founded year: 2018
Funding: £11M
Based out of Nottingham, Deep Branch Biotechnology, a carbon dioxide recycling company uses microorganisms to convert CO2 into high-quality products. The company addresses both the sustainability of animal farming and the reduction of carbon dioxide emissions with their CO2-to-protein technology.
Last month, Deep Branch completed an €8 million (nearly £7 million) Series A investment round led by Novo Holdings and DSM Venturing alongside participation from Total Carbon Neutrality Ventures and Barclays Sustainable Impact Capital. The fund will be used to complete Deep Branch’s Scale-Up Hub at the Brightlands Chemelot Campus (Limburg, NL).

The Collaborative
Founder/s: Edward Averdieck, James Averdieck
Founded year: 2014
Funding: £5.5M
London-based dairy business The Collaborative formerly known as The Coconut Collaborative works with the mission to create vegan coconut-based yogurts, ice creams, and other desserts. In early 2020, the dairy company bagged $7 million (nearly £5 million) Series A investment from PowerPlant Ventures. The Collaborative announced that the investment will be used for the expansion of its business in the US and expand its leadership team too.

THIS
Founder/s: Andy Shovel, Pete Sharman
Founded year: 2019
Funding: £10.6M
London-based THIS makes plant-based food for meat lovers. It creates one of the most realistic bacon and chicken alternatives in the world as per the company. THIS uses soya beans and peas to mimic meat in terms of texture, taste, smell and appearance sans impacting the environment.
In 2020, THIS pocketed €3.8 million (nearly £3.3 million) funding on Seedrs from VC firms including Backed, Five Seasons Ventures, Idinvest Partners, Seedcamp and Manta Ray Ventures. The company intends to accelerate growth with this funding round.

Hoxton Farms
Founder/s: Ed Steele, Max Jamilly
Founded year: 2020
Funding: £2.7M
London-based Hoxton Farms combines cell biology and mathematical modelling to create a better type of fat. It grows purified animal fat in bioreactors to come up with cruelty-free, delicious and sustainable ingredients.
Back in February this year, Hoxton Farms raised £2.7 million seed round to cultivate animal fat and solve a sustainability issue for the rapidly growing market of meat alternatives.

Purezza
Founder/s: Tim Barclay
Founded year: 2015
Funding: £2.5M
Based in Brighton, Purezza was founded as the first vegan pizzeria in the UK. Now, it operates restaurants in vegan hotspots such as Bristol, Brighton, Camden, and Hove. Purezza claims to have spent over two years developing its own-line of mozzarella.
In October 2020, MVK Group, a holdings company in London and Veg Capital completed a funding round of £2.4 million into the pizza chain Purezza. It announced that the investment will be used for the retail expansion of Purezza’s mozzarella, which will see a brand new 8,000 square foot retail space.

Entocycle
Founder/s: Keiran Olivares Whitaker
Founded year: 2015
Funding: £1.9M
Based out of London, Entocycle is a sustainable pet food alternative, an insect farming company that operates with the mission to defend and restore the natural world. It was launched to farm insects as a sustainable alternative to soy and fishmeal and to put an end to the industrial plundering of the natural world. The company is building a new insect farming facility that will be used to raise black soldier flies. These flies will be fed on food waste to create sustainable insect protein.
Entocycle announced £10 million funding from UK Government’s Industrial Strategy Challenge Fund (ISCF) in 2020. The funding round will be used to help fund the construction of a large-scale industrial insect farm that can produce insects for animal feed.
Better Dairy
Founder/s: Christopher Reynolds, Jevan Nagarajah
Founded year: 2019
Funding: £1.6M
Better Dairy is a London company that uses yeast fermentation to produce cheese, ice creams and yoghurt as dairy without using animals. This company comes to play at a time when dairy production is highly inefficient and unsustainable.
In 2020, Better Dairy announced it raised £1.6 million in seed funding for its animal-free dairy production. Also, Happiness Capital participation from CPT Capital, Stray Dog Capital, Veg Capital, and undisclosed angel investors. The funding will be used to increase R&D efforts of its animal-free dairy production and produce dairy products that are molecularly identical to dairy made.

SuSeWi
Founder/s: Keith Coleman, Raffael Jovine
Founded year: 2013
Funding: £4M
SuSeWi from London is a sustainable food from microalgae. In July last year, the company announced the successful completion of its $3 million (nearly £2.2 million) Series A fundraise. The Lichtenstein Global Trust, an existing investor, increased their proportional holding, and contributed an additional $800,000. The company will use the investment to complete construction of its pilot plant in Morocco, undertake further research into microalgae.